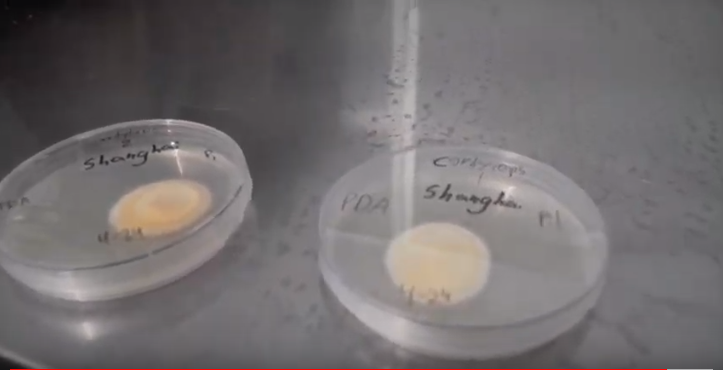

Are you interested in growing cordyceps? We have some information for you, including reasons why people love cordyceps and tips on media preparation
Cordyceps is a mushroom that is EXPLODING in popularity in the United States for both cultivation and consumption. More and more cordyceps can be found as a supplement in coops and other grocery stores. Social media is filled with people trying to figure out how to cultivate cordyceps. So the team at Fungi Ally decided to take a look and see if we could contribute to the research and information coming out around this mushroom.
We have looked at growing cordyceps effectively on a commercial scale, what the subjective impacts are when we consume cordyceps, and what is behind this explosion of popularity. What we found is summarized below.
Reasons behind the interest in growing cordyceps
-
Growing cordyceps commercially is still in its infancy in the United States. With the high cost of labor and current labor intensive methods, cordyceps cannot be commercially cultivated as shiitake or oyster are. Cordyceps can certainly be cultivated by a home grower and some commercial growers that have access to a high value market.
-
Cordyceps is a tasty mushroom that makes a great broth. The broth tastes a lot like chicken bone broth. Completely subjectively, an increase in energy and a brightness in colors after consuming cordyceps was noticed!
-
The excitement around growing cordyceps is driven by a variety of factors. None of the factors are supported by western scientific research. This doesn’t necessarily mean they don’t have validity, but should be approached with the understanding that people are formulating opinions based on their own experiences and interests.
So, what factors are increasing the consumption and cultivation of this mushroom? As always, money is a player. Cultivation is increasing because of the potential of cordyceps to be a high-value crop. It is extensively used in supplements, which are all currently coming from China or derived from the mycelium instead of the fruiting body. Wild cordyceps is priced similarly to gold, so the availability of cultivated cordyceps for a relatively affordable price has many people consuming this mushroom. The assumption here is that cordyceps militaris and cordyceps sinensis contain similar compounds and have similar effects in the body. Another factor is the growing popularity of specialty mushrooms in general. More consumers are consuming specialty mushrooms as supplements and looking at them as a source of medicine. Cordyceps has a history of being used and revered for its impacts on the body. Cordyceps is a new mushroom which makes the consumption and cultivation of it exciting. Both growers and consumers that want to be on the cutting edge are exploring this mushroom to become an early adopter.
Growing cordyceps in seven steps
Growing cordyceps involves an easier method of cultivation than most specialty mushrooms. The difficult parts are finding a strain that will fruit and growing cordyceps at a commercial scale. To successfully grow cordyceps for home cultivation is pretty straight forward. It requires only two things: a viable spawn and, ideally, a pressure cooker, though even a normal pot could be used instead. This section will progress based on the seven stages of cultivation laid out in Tradd Cotter’s book
Organic Mushroom Farming:
- Media preparation
- Inoculation
- Spawn run
- Full colonization
- Pinning
- Fruiting
- Rest
Media Preparation for growing cordyceps
Picking a good media recipe is crucial to getting good yields while growing cordyceps. During all trials we used the formula below, recommended by William Padilla-Brown.
- 1 gallon water
- 1/2 cup starch
- 1/4 cup nutritional yeast
- 2 tbsp sugar
- 2 tbsp azomite
- 5 scoops baby food
This makes 72 pint jars.
First, 2 TBSP rice was placed in wide-mouth pint jars. Next, all other ingredients were mixed in a large mixing bowl until they were dissolved. Finally, a ¼ cup of the liquid was poured into each Mason jar. The lid with a polyfill filter is placed on top of the jar and screwed on. The jar is then loaded into the sterilizer. Polyfill is used to stuff many pillows and can be purchased at most big department stores. A hole is punched into the top of the lid of a jar using a screwdriver and then a ball of the polyfill is pressed into this hole so it is sticking out of both the top and bottom. This acts as a low-budget air filter.
Sterilization was done in a 28-quart All American sterilizer. The temperature was brought up to 250 degrees Fahrenheit and maintained for about 3 hours. The cooker was then allowed to cool overnight before inoculation. If attempting to commercialize cordyceps cultivation, another possibility for this step is to use atmospheric steam to treat the media instead of a pressure cooker or autoclave.

The container we used for growing cordyceps
In one set of trials we attempted to develop a new container in which to cultivate cordyceps. We trialled trays, bags, and jars. Both the tray and bags failed to colonize. The bags would be a huge benefit because over 100 can fit into the sterilizer at a time. With jars, only 24 could fit in the sterilizer. Not needing to wash jars would also reduce overall time in the cultivation process.
The biggest difficulty was getting the spawn (an agar wedge) in contact with the growing media at the bottom of the bag. Unicorn 10A bags were used, which are 18 inches tall. By using a much shorter custom bag, this problem may be addressed. The trays were all contaminated because of lack of filtration. Other growers in the US and around the world have successfully used tray cultivation and this could be a good route for growers interested in commercial cultivation. In these setups, bread pans are typically covered with aluminum foil and sterilized, the aluminum foil is peeled back slightly to inoculate and then placed back around the pan. The entire pan is then placed into a plastic bag and tied off.